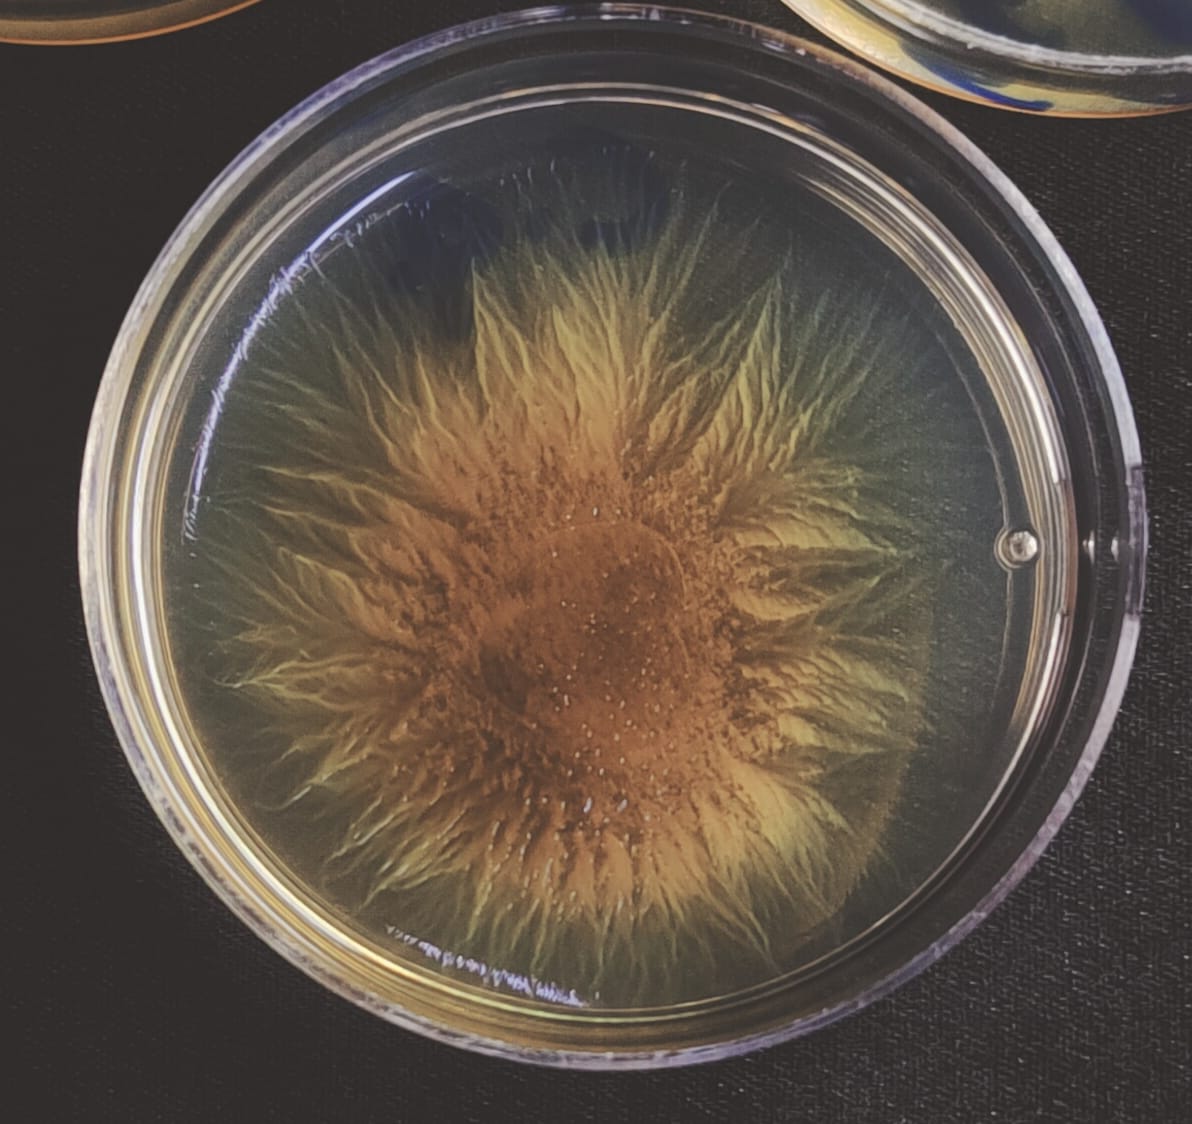

7 January 2026
Kavi Bharathi R
Microbes often display cooperative behaviour in which individual cells put in work and sacrifice resources to collectively benefit the group. But sometimes, “cheater” cells in the group may reap the benefits of this cooperation without incurring any cost themselves. Scientists have suggested that in such cases, population bottlenecks – reduction in the total number of individuals – can help stabilise cooperative behaviour in the group.
A new study in PLOS Biology reveals that population bottlenecks can fundamentally reshape how cooperation evolves and persists in complex microbial societies. Researchers at the Indian Institute of Science (IISc) explored how repeated bottlenecks affect cooperative traits of Myxococcus xanthus, a model social bacterium known for its remarkable coordinated hunting ability and spore formation inside multicellular fruiting bodies.
M. xanthus swarm on soft agar plate (Photo: Jyotsna Kalathera)
“A population bottleneck refers to a drastic and sudden reduction in both the size and diversity of the population. If there are ways to purge out cheaters from the population … this would be one of the ideal ways to do it,” says Jyotsna Kalathera, former PhD student at the Department of Microbiology and Cell Biology (MCB), and first author of the study.
“Floods and forest fires reduce population size massively in the wild. When we talk about macroecosystems of plants, animals, bears, and tigers, it is challenging to test any of these hypotheses; you have to use a more conceptual approach, and you use microorganisms to answer these questions,” explains Samay Pande, Assistant Professor at MCB and corresponding author of the study.
By designing long-term evolution experiments, the team compared Myxococcus populations that underwent stringent bottlenecks (in which very few survive in each successive cycle) versus relaxed bottlenecks (more survivors in each cycle). These bottlenecks were artificially created in the lab by selecting a specific lower number of bacteria to be cultured in each subsequent generation. Across both conditions, four major cooperative traits were studied: sporulation, germination, predation, and growth.
The team found that under stringent bottlenecks, fruiting body formation and growth were favoured, whereas predation and germination declined, producing more homogeneous populations of cooperative individuals. In contrast, relaxed bottlenecks reversed this pattern, which led to an overall increase in competitive fitness or infighting for resources across the organism’s life cycle.
“In this study, we have figured out genetic changes that are associated with how the stringent and relaxed bottlenecks affect cooperative traits, but we have not yet unravelled their molecular basis,” adds Pande.
The findings advance our understanding of how population dynamics influence the evolution of microbial traits and offer new insights into the maintenance of cooperation in natural microbial communities.
“Cooperation is essential in the context of the evolution of life. Multiple genes must work together to form chromosomes, and cells need to collaborate to create multicellular organisms,” adds Pande.

From left to right: Neha Mandal, Jyotsna Kalathera, Samay Pande (Photo: Kavi Bharathi R)
REFERENCE:
Kalathera J, Jaiswal P, Mandal N, Patel V, Guttal V, Krishna S, Pande S, Bottleneck size drives the evolution of cooperative traits in an aggregative multicellular myxobacterium, PLOS Biology (2025).
https://journals.plos.org/plosbiology/article?id=10.1371/journal.pbio.3003499
CONTACT:
Samay Pande
Assistant Professor
Department of Microbiology and Cell Biology (MCB)
Indian Institute of Science (IISc)
Email: samayp@iisc.ac.in
Phone: 080-22932415
Website: https://www.redqueenlab.com/
NOTE TO JOURNALISTS:
a) If any of the text in this release is reproduced verbatim, please credit the IISc press release.
b) For any queries about IISc press releases, please write to news@iisc.ac.in or pro@iisc.ac.in.